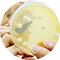

Qué hacemos
Angel Yeast
Aprovechamos al máximo la biotecnología, centrándonos en la investigación y aplicación de la tecnología de levadura, que desarrolló la levadura a nivel mundial y los productos de procesamiento profundo.
Nuestros productos son ampliamente utilizados en panadería, saborización de alimentos, nutrición y salud y biotecnologías...